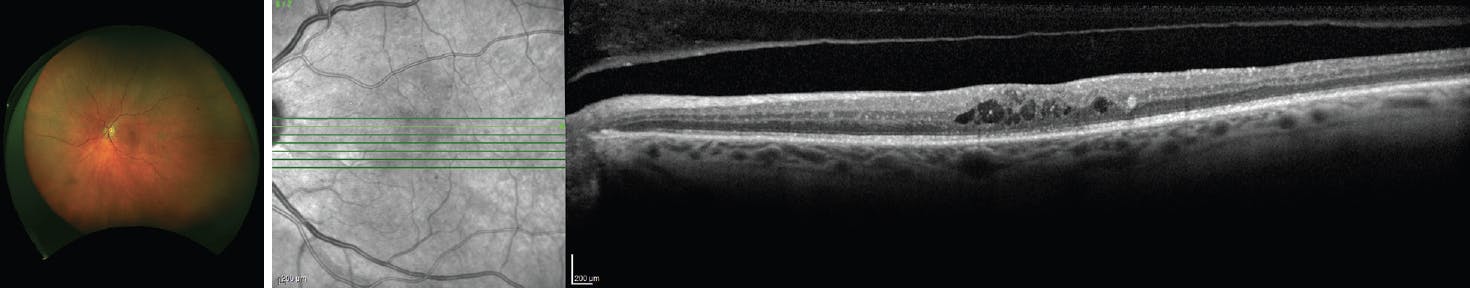

AT A GLANCE
- The Diabetic Retinopathy Clinical Research Retina Network researchers have proposed definitions for strong and weak phenotypic responses to anti-VEGF therapy for diabetic macular edema (DME), both in terms of letter gains and reductions in central subfield thickness (CST).
- These new definitions can be used to inform patients with DME and future investigations into DME treatment responses.
- At 104 weeks, only 69% of patients with DME who initially had a strong visual acuity and CST response maintained that response.
Anti-VEGF treatments such as bevacizumab (Avastin, Genentech/Roche), ranibizumab (Lucentis, Genentech/Roche), 2 mg aflibercept (Eylea, Regeneron), faricimab-svoa (Vabysmo, Genentech/Roche), and now 8 mg aflibercept (Eylea HD, Regeneron) have revolutionized the way we treat center-involving diabetic macular edema (CI-DME). However, despite adequate treatment, many patients may not achieve 20/20 vision or may have residual fluid. For example, strong responses for patients starting with a baseline VA of 20/30 may be different in terms of letters gained or reduction in intraretinal fluid because of a ceiling effect. The magnitude of response to treatment will differ for each patient depending on their starting point (Figures 1 and 2).
Figure 1. A 59-year-old man with type 2 diabetes presented with CI-DME in the left eye. His VA was 20/40, and CST on spectral-domain OCT measured 348 µm.

Figure 2. Four weeks after a single anti-VEGF injection of 2 mg aflibercept, the patient exhibited a strong response with a VA of 20/20-2 and CST of 294 µm.
What makes some patients strong responders when it comes to vision gains and fluid reduction and others weak? To help answer this question, we must first uncover what determines a strong versus a weak response. Once we have a treatment response paradigm, we can determine if patient-specific or other parameters influence a strong response.
THE INITIAL DATA
Researchers from the Diabetic Retinopathy Clinical Research (DRCR) Retina Network, led by Jennifer K. Sun, MD, MPH, set out to determine how to better characterize these responses and published their results in Retina.1 They conducted a retrospective review of patients treated with anti-VEGF therapy in the DRCR Protocols I, T, and V and evaluated several outcomes after treatment. The anti-VEGF treatments used included ranibizumab in Protocol I; bevacizumab, ranibizumab, and 2 mg aflibercept in Protocol T; and 2 mg aflibercept in Protocol V. All eyes were treated using the DRCR treatment protocol, which included change in visual acuity ETDRS letters; change in visual acuity ETDRS letters under the curve; gains of at least 5, 10, or 15 letters; change in central subfield thickness (CST); change in CST relative to baseline; and reduction in CST of at least 50 µm, 100 µm, or 200 µm.1
The baseline characteristics of the patients were mostly similar with a few differences. There were slightly more men (54%) than women, and 32% were non-White race or Hispanic ethnicity. In terms of the anti-VEGF agent received, 51% received ranibizumab, 28% received 2 mg aflibercept, and 21% received bevacizumab. Approximately a quarter (26%) had excellent baseline vision (20/25 to 20/32), half (51%) had good vision (20/40 to 20/63), and another quarter (23%) had poorer baseline vision (20/80 to 20/320). In terms of DME above the DRCR thresholds for CI-DME, about one-third of patients had mild edema (0 µm to < 75 µm over the threshold), one-third had moderate edema (75 µm to < 175 µm over the threshold), and one-third had severe edema (> 175 µm over the threshold).1
There was a varied response in improving visual acuity and reducing CST at 24 weeks. Interestingly, approximately half of the patients with initial excellent visual acuity (20/25 to 20/32) gained at least 5 letters, half of the patients with initial good acuity (20/40 to 20/63) gained at least 10 letters, and half of the patients with initial poorer visual acuity (20/80 to 20/320) gained at least 15 letters. These patients were defined as having a strong response in terms of visual acuity gains (Table 1).1
As for the reduction in CST at 24 weeks, approximately half of the patients with mild, moderate, and severe baseline DME had a fluid reduction of at least 50 µm, 100 µm, and 200 µm, respectively. These patients were defined as having a strong response in terms of fluid reduction (Table 2).1
Overall, at 24 weeks, 32% of patients were determined to have a strong response in terms of visual acuity gain and CST reduction, 18% had a strong visual acuity response but a weak CST response, 21% had a weak visual acuity response but a strong CST response, and 29% had a weak visual acuity and CST response.1
ONGOING TREATMENT
What happens as patients continue to get treatment? Do all patients who initially have strong visual acuity and CST responses maintain that later in their treatment course? The latest data suggests otherwise. At 104 weeks, only 69% of patients who initially had a strong visual acuity and CST response maintained that response. Of those with an initial strong visual acuity and CST response, 7% converted to a weak visual acuity and weak CST phenotype. Of those with an initial weak visual acuity and weak CST response, 40% stayed that way at 104 weeks while 21% converted to a strong phenotype.1
Even considering visual acuity and CST gains separately, patients experienced changes in phenotype with time. In those with a strong visual acuity response at 24 weeks (regardless of CST response), 77% maintained that response at 104 weeks. Of patients with an initial weak visual acuity response at 24 weeks (regardless of CST response), 40% had a strong response at 104 weeks. As for CST gains, 81% of patients with an initial strong response at 24 weeks (regardless of visual acuity response) maintained that response at 104 weeks. Of patients with an initial weak CST response at 24 weeks (regardless of visual acuity response), 42% converted to a strong response phenotype at 104 weeks.1
The total number of anti-VEGF injections received varied based on the protocol but had no clear relationship to the treatment response.
CLINICAL IMPLICATIONS
The current study provides some valuable insights and tools to assist retina specialists in managing CI-DME.
First, the authors propose definitions for strong and weak phenotypic responses in terms of letter gains and reductions in CST. These definitions account for the baseline vision and CST to ensure they are more applicable to all patients, even those with good starting vision and limited DME.
Second, this assists in counseling patients who are starting treatment. Based on the above data, clinicians can advise patients that there is approximately a 50% chance that they will have a strong response after treatment for approximately 6 months. Clinicians can further counsel patients that if they have a strong response in terms of vision acuity, there is approximately a 75% chance they will maintain that for 2 years of treatment. If they don’t have an initial strong visual acuity response at 6 months, there is a 40% chance they will start to have a strong response at 2 years, highlighting that eyes with an initial suboptimal response can improve substantially with continued treatment. These numbers can help patients better understand what the future may hold and what they can expect in terms of visual acuity gains.
Third, the definitions of strong and weak responders to anti-VEGF therapy for DME can be used to inform future investigations into DME treatment responses, thus functioning as a powerful research tool.
This analysis does not delve into patient-specific characteristics, such as age or hemoglobin A1c, which may inform why some patients have a strong response and others don’t; these definitions could be applied to future research efforts to gauge which patients will be strong and which will be weak responders to therapy.
Overall, this report adds to the growing body of knowledge about CI-DME and patient response to anti-VEGF therapy. It may prove particularly useful when it comes to prognosticating outcomes after treatment.
1. Sun JK, Beaulieu WT, Melia M, et al. Defining “strong” versus “weak” response to antivascular endothelial growth factor treatment for center-involved diabetic macular edema. Retina. 2023;43(4):616-623.



























